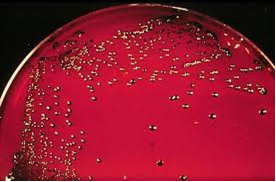
Bacteroides melaninogenicus

|
ANAEROBNI, ASPOROGENI GRAM-NEGATIVNI ŠTAPIĆI
(BACTEROIDES SPP, FUSOBACTERIUM SPP)
Bakterije su najsitniji jednoćelijski organizmi, spadaju
u prokariote. Iako jednoćelijska živa bića, vrše sve osnovne
životne funkcije koje vrše i najrazvijena višećelijska živa bića: hrane
se, dišu, prozvode i troše energiju, kreću su, razmnožavaju.
Porodicu Bacteroidaceae čine Gram-negativni,
asporogeni striktno anaerobni štapići, od kojih su neki pokretni, a neki
nepokretni. Brojne različite vrste se nalaze u toj porodici. Prema
9. Izdanju Bergyevog Priručnika Sistematske Bakteriologije od 1984. godine
ova porodica se nalazi u 6. Sekciji pod nazivom „Anaerobni Gram-negativni
pravi, savijeni i zavijeni štapići“. Označeni rimskim brojevima od
I do XIII, u ovoj porodici se nalazi 13 rodova, a za humanu medicinu su
najvažnija prva tri roda: Bacteroides, Fusobacterium
i Leptotrichia; Leptotrichia je od manjeg značaja nego prva dva.
Veliki broj pripadnika porodice Bacteroidaceae su bakterije normalne ili
fiziološke mikroflore gornjih dijelova respiratornog i urogenitalnog trakta
te debelog crijeva, kako čovjeka tako i mnogih životinja. Međutim, neke
vrste, nekih rodova, u uslovima od kojih su neki poznati, a neki nisu,
mogu izazvati lakše ili teže lezije na sluznicama tkiva i organa ljudi
i životinja. Na ovaj način nastale infekcije mogu biti veoma teške i obimne.
Uzročnici tih infekcija često mogu prodrijeti i u krv, čime izazivaju
teške oblike septihemije. Uzročnici navedenih promjena najčešće ostaju
neotkriveni i neidentifikovani jer se dešava da mnoge mikrobiološke laboratorije
bolesnički materijal, u kome se nalaze te bakterije, ne ispituju i u anaerobnim
uslovima.
Bakterijske vrste rodova ove porodice morfološki su veoma heterogene,
najčešće imaju oblik štapića, kraćih, dužih ili veoma dugačkih. Štapići
mogu biti veoma kratki, na obamkraja zašiljeni te imaju oblik vretena.
Filamentski oblici se često račvaju, a ponekad i granaju.
Glavna morfološka karakteristika pripadnika porodice Bacteroidaceae
je pleomorfizam. Njihova morfologija u velikoj mjeri zavisi i od vrste
podloge na kojoj se razmnožavaju kao i od kvaliteta i kvantiteta njenog
sastava.
Neke vrste ove porodice razmnožavaju se na mnogim podlogama, a neke samo
na ili u posebno obogaćenim hranilištima. Takve zahtjevaju razne dodatke
podlogama na kojima se kultivišu (ekstrakti gljiva, krv, obavezno glikoza
i cistein; neke vrste mogu opstati samo ako se podlogama dodaju vitamini
B-kompleksa).
Optimalna temperatura za razmnožavanje gotovo svih vrsta ove porodice
je 37ᵒC, optimalni pH je 6,2 do 7,0. Razmnožavaju se samo u strogo anaerobnim
uslovima. Dodavanje podlogama CO2 stimuliše njihov razvoj.
Također, pripadnici porodice Bacteroidaceae razlikuju se međusobno
po svojim metaboličkim osobinama, naročito po krajnjim produktima istog.
Razlikuju se i po osjetljivosti tj. otpornosti prema antimikrobnim terapeutskim
sredstvima. Takve razlike se mogu koristiti za razlikovanje tj. identifikaciju
i diferencijaciju pojedinih rodova, vrsta i podvrsta ove porodice.
U nastavku slijedi više o dva medicinski najvažnija roda porodice Bacteroidaceae,
a to su kako je ranije navedeno: Bacteroides i Fusobacterium.
1. BACTEROIDES
Godine 1919. Autori Castellani i Chalmers su opisali
prve bakterije ovoga roda. U ovome rodu se nalaze pokretljive i nepokretljive
štapićaste bakterije sa peritrihijalnim flagelama. Znatan dio normalne
flore čovjeka čini većina vrsta ovoga roda. U simbiozi s drugim aerobnim
i anaerobnim bakterijama izazivaju češće infekcije mekih tkiva, što naravno
mogu izazivati i same. Prema listi naziva bakterija, u ovom rodu se nalaze
33 vrste, a više od polovine njih je patogeno za čovjeka i razne životinje.
Bakterije ovoga roda su štapići dužine 1,5 do 5,0 μm, širine oko 0,5 μm.
Odlikuju se veoma izražnim pleomorfizmom. Javljaju se u kokobacilarnom
obliku kao i u vidu produženih pa i veoma dugaćkih štapića. Filamentski
oblici se često vide, oni se račvaju a nekada i granaju. Također mogu
biti i kratki štapići koji su u sredini zadebljani pa po obliku podsjećaju
na vreteno. U njima se obično nalazi određeni broj vakuola; nemaju kapsule,
flagele i nepokretni su. Od podloge, vrste i sastava, na kojoj se kultivušu
uveliko ovisi njihova morfologija; što je podloga siromašnija, to je pleomorfizam
jače izražen. Na i u bogatim podlogama bakterije ovoga roda su duže.
Većina vrsta roda Bacteroides nalazi se u raznim šupljinama organizma
čovjeka i mnogih životinja, naročito u debelom crijevu gdje ih može biti
1010/1 g sadržaja čime znatno premašuju broj aerobnih i fakultativno anaerobnih
bakterija crijeva. U fecesu ljudi i mnogih životinja su prisutni u velikom
broju; prisutni su i u otpadnim tj. fekalnim vodama.
Bakterije roda Bacteroides nisu direktno patogene, one su oportunisti.
U slučaju da promjene mjesto svog normalnog boravka, dospiju na mjesto
gdje nisu redovne, izazivaju razne infekcije. Patogene mogu postati i
kada djeluju u simbiozi sa raznim aerobnim ili fakultativno anaerobnim
bakterijama inače normalne mikroflore čovječjeg tijela. Do infekcije ovim
bakterijama može doći i u slučaju pada opće otpornosti čovjeka izazvanog
iz bilo kojeg razloga.
Za humanu medicinu najvažnije su slijedeće vrste roda Bacteroides: Bacteroides
fragilis, Bacteroides oralis, Bacteroides melaniogenicus
i Bacteroides corrodans. A značajne su i vrste: Bacteroides
distasonis, Bacteroides ovatus, Bacteroides thetaiotaomicron i Bacteroides
vulgatus. Identifikacija i diferencijacija pojedinih vrsta vrši se
mikroskopski, biohemijski i pomoću hemiograma. Za identifikaciju je veoma
važna identifikacija masnih kiselina što se vrši pomoću gasnog hromatografa.
1.1. Bacteroides fragilis
Bakterije ove vrste su prilično dugačke, od 2,0 do 5,0 μm. Među njima
su rijetki kokidni oblici, a češće se javljaju u vidu kokobacila sa zadebljanjem
u sredini. U njima se nalaze vakuole; boje se neravnomjerno i Gram-negativne
su.

Ilustracija 1, Bacteroides fragilis
Na krvnom agaru, poslije inkubacije od 24 sata, na 37 C, obrazuju se
okrugle, konveksne, mat kolonije; prozračne su, sive boje i glatkih ivica;
prečnika 1,0 do 3,0 mm. Imaju miris na koprivu. Dodatak žuči ili žučnih
soli stimuliše njihovo razmnožavanje.
Ove bakterije od šećera razgrađuju saharozu, indol ne formiraju, a nitrate
ne redukuju u nitrite.
Nalaze se u usnoj šupljini i u intestinalnom traktu, gdje žive manje više
kao stalni stanovnici normalne mikroflore čovjeka.
U drugim uslovima, sama ili u simbiozi s drugim bakterijama, može izazvati:
apendicitis, peritiflitis, peritonitis, moždani apsces, pleuralni empijem,
adneksitis u žena, osteomijelitis kao i inflamacije i gnojenje u zubnom
korijenu karioznih zuba.
1.2. Bacteroides oralis
Bakterije ove vrste su kratki štapići od 0,2 do 0,4 μm kao i znatno duži,
2,0 do 5,0 μm. Pokazuju veoma izražen pleomorfizam.
Poslije inkubacije na krvnom agaru, od 48 sati na 38 C, obrazuju se velike,
okrugle, nešto konveksne, žućkasto-sive glatke kolonije sa glatkom i ravnom
ivicom. Oko tih kolonija se ne formira hemoliza. Dodatak žuči ili žučnih
soli stimuliše razmnožavanje i bakterije ove vrste.
Bakterije ove vrste razgrađuju mnoge ugljične hidrate, nitrate ne redukuju
u nitrite, a indol ne proizvode.
Bacteroides oralis predstavlja dio normalne flore probavnog trakta čovjeka.
Može izazvati gnojne infekcije mekih tkiva.

Ilustracija 2, Bacteroides oralis
1.3. Bacteroides melaninogenicus
Ova je vrsta podijeljena u tri podvrste prema razlikama u biohemijskim
osobinama te različitim produktima masnih kiselina, a to su: Bacteroides
melaninogenicus subsp. melaninogenicus, Bacteroides melaninogenicus subsp.
intermedius i Bacteroides melaninogenicus subsp. levii.
Bakterije ove vrste čine mješavinu štapićastih i kokobacila. Na krvnom
agaru sporo grade kolonije. Tek nakon inkubacije od četiri dana, na 37
C obrazuju okrugle, konveksne, glatke, sive prozračne kolonije; njihov
prečnik je 0,5 do 2,0 mm. Kolonije nakon 14 dana inkubacije dobivaju crnu
boju zbog pojave hematina. Ovaj crni pigment je veoma karakterističan
za ovu vrstu roda Bacteroides čime olakšava nj. identifikaciju i izolaciju,
a dodavanje hemina i menadiona stimuliše navedenu pigmentaciju. Dodavanje
hranjivoj podlozi žuči ili žučnih soli simuliše razmnožavanje i ove vrste
roda Bacteroides.
Bacteroides melaninogenicus razgrađuje trehalozu, ramnozu i saharozu.
Ne produkuje indol a nitrate ne redukuje.
Ova bakterija se normalno nalazi u usnoj šupljini i u crijevima. Izaziva
suprativne lezije mekih tkiva, a često i apscese.
Ilustracija 3, Bacteroides melaninogenicus
1.4. Bacteroides corrodans
Bakterije ove vrste su kokoidnog oblika ili tanki štapići dugački 1 do
3 μm, a široke su 0,5 μm.
Poslije inkubacije 4 do 5 dana na krvnom agaru obrazuju sitne kolonije,
prečnika 1 mm i urasle u podlogu. Pojedine kolonije nakon još nekoliko
dana počinju da se roje, slično kolonijama Proteusa; pri čemu njihova
površina poprima boju duge.
Ova vrsta ne razgrađuje ni jedan šećer, redukuje nitrate, produkuje ureu,
i ne stvara indol. Žuč nema nikakvog utjecaja na razmnožavanje bakterije
ovoga roda.
Bacteroides corrodans je normalni stanovnik usne šupljine i probavnog
trakta, izaziva abscedirajuće infekcije na sluznicama i u raznim drugim
tkivima.
2. FUSOBACTERIUM
U rodu Fusobacterium nalaze se Gram-negativni štapići, gdje nj. glavni
oblik ima izgled vretena, ali se javljaju i u vidu kratkih ili osrednje
dugih štapića. Neke vrste nemaju flagela pa su nepokretne, druge imaju
peretrihijske flagele i pokretne su. Sve bakterije ovoga roda su asporogene.
Nemaju kapsulu. Pored opisanih nalaze se i srednje dugački štapići sa
zaobljenim krajevima, ove pokazuju veoma izražen pleomorfizam.
Ove bakterije uspijevaju samo na podlogama koje sadrže izvorne bjelančevine.
Potrebni su im anaerobni uslovi, mada nisu sve vrste jednako osjetljive
na kisik. Optimalna temperatura je 37 C, i optimalni pH je 7,0. Poslije
inkubacije od 24 do 48 sati obrazuju sitne prozračne kolonije.
Bakterije ovoga roda su proteolitičke. Imaju slabo izražene fermetnativne
osobine. Razgrađuju samo neke šećere, proizvode maslačnu kiselinu što
je za ove bakterije glavna karakteristika. U manjim količinama stvaraju
se i druge kiseline u manjim količinama.
Sve bakterije roda Fusobacterium su osjetljive na mnoge antibiotike, a
posebno na betalaktamatske i na colistin.
Ove bakterije su dio normalne mikroflore a nalaze se u crijevima i usnoj
šupljini. Također se nalaze u gnoju i sekretima inficiranih tkiva i organa.
Poput vrste roda Bacteroides i bakterije ovoga roda su oportunisti, mogu
proizvesti razne infekcije u raznim tkivima i organima ako do njih prodru
tj. nađu se van mjesta svog stalnog, normalnog, boravka ili ako se udruže
s drugim anaerobnim ili fakultativno anaerobnim bakterijama.
U rodu Fusobacterium nalazi se 16 vrsta. Najvažnije vrste koje izazivaju
oboljenja kod ljudi su: Fusobacterium nucleatum, Fusobacterium necroforum
i Fusobacterium varium.

Ilustracija 4, Fusobacterium
2.1. Fusobacterium nucleatum
Bakterije ovoga roda su neravnomjerno bojeni Gram-negativni štapići čija
dužina iznosi 3 do 4 μm, a širina oko 0,5 μm, međutim, javljaju se i znatno
duži štapići 7 do 12 μm. Najčešće imaju oblik vretena.
Na krvnom agaru, nakon inkubacije od 2 do 4 dana, formiraju okrugle, konveksne,
prozračne kolonije sa neravnim ivicama prečnika od 1 do 2 mm. Granulisane
su i oko kolonija se obrazuje alfa-hemoliza.
Od ugljičnih hidrata slabo razgrađuje glikozu, galaktozu kao i fruktozu.
Neki sojevi fermentišu, a neki ne maltozu; proizvode indol i H2S. Ne redukuju
nitrate i ne rastapaju želatin. Karakteristične su po proizvodnji maslačne
kiseline, a pored nje produkuju i veoma male količine sirćetne, propionske
i sukcinične kiseline.
Često se nalaze u usnoj šupljini, a rijetko u drugim šupljinama i nekim
drugim tkivima. Ova bakterija rijetko sama izaziva infekcije, a kada se
udruži s drugim anaerobnim ili fakultativno anaerobnim bakterijama izaziva
razna oboljenja u mnogim tkivima kod čovjeka. Zajedno sa spirohetama usne
šupljine izaziva ulcerativni stomatitis i Plaut-Vincentovu anginu.

Ilustracija 5, Fusobacterium nucleatum
2.2. Fusobacterium necrophorum
Bakterije ove vrste najčešće se javljaju u dva različita vida. U jednom,
to su štapići dugi 1,5 do 3,0 μm i široki 0,5 do 1,0 μm. drugi oblik čine
filamentski oblici dugi 10 do 100 μm. pored ta dva oblika javljaju se
i vretenaste bakterije kao i kraći ili duži zavijeni štapići. Ne produkuju
sporu, nemaju flagelu i nisu inkapsulirane, boje se nepravilno i Gram-negativne
su.
Na krvnom agaru, poslije inkubacije od 24 do 48 sati, na 37 C, kod pH
7,5 do 7,8, u striktno anaerobnim uslovima, obrazuju okrugle konveksne
kolonije sa prečnikom 2 do 3 mm. Središte kolonija je nešto izdignuto,
a oko kolonija se ne obrazuju hemoliza.
Bakterije ove vrste fermentišu glikozu, fruktozu, maltozu i galaktozu
sa produkcijom gasa. Redukuju nitrate, proivode indol, a neki od spojeva
su proteolitički. Također proizvode maslačnu i propionsku kiselinu.
Normalna sredina im je usna šupljina kao i druge šupljine kod ljudi. Izazivaju
stomatitise, cistitis, apendicitis, gnojni pleuritis i septikemiju.

Ilustracija 6, Fusobacterium necrophorum
2.3. Fusobacterium mortipherum
Bakterije ove vrste razlikuju se malo ili nikako, morfološki, od bakterija
vrste necrophorum, a po kulturelnim osobinama su vrlo slične navedenoj
vrsti. Fermentišu glikozu uz proizvodnju gasa, također glukozu, fruktozu,
galaktozu, maltozu, laktozu, saharozu i rafinozu; ne proizvode indol.
Prirodno se nalaze na istim mjestima gdje i bakterije vrste Fusobacterium
necrophorum.
One izazivaju gnojne infekcije raznih tkiva i organa kao što su stomatitis,
apendicitis, cistitis, gnojni pleuritis i septikemiju.
2.4. Fusobacterium varium
Po svojim morfološkim i kulturelnim osobinama bakterije ove vrste ne
razlikuju se od bakterija vrste necrophorum.
Fermentišu glukozu uz proizvodnju gasa, također fruktozu i galaktozu;
i proizvode indol. Normalno se nalazi u u snoj šupljini i rijetko kada
je patogen.

Tabela 1, Grupne karakteristike nekih rodova i
vrsta porodice Bacteroidaceae

Tabela 2, Biohemijski testovi značajni za identifikaciju
vrsta rodova porodice Bacteroides
3. MIKROBIOLOŠKA DIJAGNOZA INFEKCIJA
Mikrobiološka dijagnoza infekcija izazvana vrstama rodova porodice
Bacteroidaceae
Materijal koji se upućuje na pregled, pri sumnji na infekcije izazvane
bakterijama pojednih vrsta rodova porodice Bacteroidaceae, zavisi od kliničkog
oblika i lokacije infekcije. Da bi se izolirala i identifikovala bakterija
iz ove porodice te postavila valjana mikrobiološka dijagnoza neke infekcije
izazvane jednom od vrsta ove porodice, veoma je važno uzimanje i slanje
odgovarajućeg materijala.
Načelo je da se uzima i šalje onaj materijal gdje normalno nema bakterija
porodice Bacteroidaceae. Za etiološku dijagnozu neke infekcije pri sumnji
da je izazvana nekom vrstom porodice Bacteroidaceae slijedeći bolesnički
materijal nije podesan za uzimanje: bris guše, aspirat bronhija, sputum,
bris usne šupljine, bris cerviksa i vagine, urin i feces. Zatim je važno
da se uzorci uzimaju, i šalju u mikrobiološki laboratorij, iz dubokih
dijelova inficiranog tkiva.
Ovaj materijal se u laboratoriji orijentaciono pregleda mikroskopski,
u nativnom preparatu i preparatu obojenom po Gramu. Potome se zasijava
u odgovarajuće tečne i na čvrste podloge. Za inkubaciju, koja u principu
traje i po nekoliko dana, najbolje je koristiti GasPak sisitem. Poslije
inkubacije obrazuju se kolonije, one se mikroskopski ispituju, biohemijski,
hemiogramski i posebno važno biohemijski na proizvodnju gasova i masnih
kiselina pomoću gasnog hromografa (navedene tabele 1 i 2).
Mikrobiološka dijagnoza, pri sumnji na infekciju vrstama rodova porodice
Bacteroidaceae, prilično je komplikovana, a posebno je složena identifikacija
izolovanog uzročnika.
3.1. Specifična terapija infekcija
Specifična terapija infekcija izazvanih vrstama rodova porodice Bacteroidaceae
Specifična terapija izazvana vrstama roda Bacteroides razlikuje se od
specifične terapije izazvane vrstama roda Fusobacterium. Antimikrobna
terapija infekcija obično je teška. Te bakterije redovno su otporne na
mnoge antibiotike i hemioterapeutike.
Cilj antimikrobnog liječenja je postizanje nivoa specifično djelotvornog
lijeka na mjestu infekcije koja je viša od minimalne efektivne (npr. inhibicijske,
baktericidne) uz podržavanje učinka lijeka do eliminacije uzročnika.
Promašivanje cilja antimikrobnog liječenja znači terapijski neuspjeh,
što pogoduje nuspojavama i razvoju rezistencije.
Većina vrsta roda Bacteroides je osjetljiva na hloramfenikol, klindamicin,
cefoksitin i metranidazol. Bacteroides fragilis je najčešće otporan i
na neka pobrojana hemioterapeutska sredstva. Obično na tu vrstu najefikasnije
djeluju velike doze cefoksitina, a posebno u obliku infuzije.
Najveći procenat bakterija vrsta roda Fusobacterium je osjetljiv na mnoge
antibiotike i hemioterapeutike, većina je osjetljiva i na peniciline,
cefalosporine i hloramfenikol kao i na tetraciline.
ZAKLJUČAK
Porodicu Bacteroidaceae čine Gram-negativni, asporogeni anaerobni štapići,
gdje su neki pokretni, a neki nepokretni. Brojne različite vrste nalaze
se u ovoj porodici.
Veliki broj pripadnika ove porodice su bakterije normalne ili fiziološke
mikroflore gornjih dijelova respiratornog i urogenitalnog trakta te debelog
crijeva. Međutim, neke vrste, nekih rodova, u uslovima od kojih su neki
i nepoznati mogu izazvati lakše ili teže lezije na sluznicama tkiva i
organa ljudi i životinja.
Glavna morfološka karakteristika pripadnika porodice Bacteroidaceae je
pleomorfizam. Njihova morfologija u velikoj mjeri zavisi i od vrste podloge
na kojoj se razmnožavaju kao i od kvaliteta i kvantiteta njenog sastava.
Sa medicinskog aspekta gledano, dva najvažnija roda porodice Bacteroidaceae,
su
Bacteroides i Fusobacterium.
Većina vrsta roda Bacteroides nalazi se u raznim šupljinama organizma
čovjeka i mnogih životinja, naročito u debelom crijevu gdje ih može biti
1010/1g sadržaja čime znatno premašuju broj aerobnih i fakultativno anaerobnih
bakterija crijeva. Bakterije roda Bacteroides nisu direktno patogene,
već su oportunisti; u slučaju da promjene mjesto svog normalnog boravka
tj. dospiju na mjesto gdje nisu redovne, izazivaju razne infekcije.
U rodu Fusobacterium su Gram-negativni štapići, gdje nj. glavni oblik
ima izgled vretena, javljaju se i u vidu kratkih ili osrednje dugih štapića.
Neke vrste nemaju flagela pa su nepokretne, druge imaju peretrihijske
flagele i pokretne su.
Bakterije ovoga roda su proteolitičke, imaju slabo izražene fermetnativne
osobine. Razgrađuju samo neke šećere i proizvode maslačnu kiselinu što
je za ove bakterije glavna karakteristika. I ove bakterije su dio normalne
mikroflore a nalaze se u crijevima i usnoj šupljini, ali i u gnoju i sekretima
inficiranih tkiva i organa. Poput vrste roda Bacteroides i bakterije ovoga
roda su oportunisti.
Mikrobiološka dijagnoza, pri sumnji na infekciju vrstama rodova porodice
Bacteroidaceae, prilično je komplikovana, a posebno je složena identifikacija
izolovanog uzročnika. Specifična terapija izazvana vrstama roda Bacteroides
razlikuje se od specifične terapije izazvane vrstama roda Fusobacterium.
Antimikrobna terapija infekcija obično je teška. Bakterije su redovno
otporne na mnoge antibiotike i hemioterapeutike. Cilj antimikrobnog liječenja
je postizanje nivoa specifično djelotvornog lijeka na mjestu infekcije,
do eliminacije uzročnika.
LITERATURA
Knjige:
1. Karakašević B. i sar., Mikrobiologija i parazitologija, VI preštampano
izdanje; Medicinska knjiga, Beograd - Zagreb 1989.
2. Hukić M. Morfološke i fiziološke osobine bakterija, Jež, Sarajevo
2005.
Tekstovi sa interneta:
1. www.sourcemolecular.com, downloaded 15/5/2012
2. www.mefmo.ba/alumni/images/obavijesti/antibiotici1.pdf, downloaded
15/5/2012
PROČITAJ
/ PREUZMI I DRUGE SEMINARSKE RADOVE IZ OBLASTI:
|
|
preuzmi
seminarski rad u wordu » » »
Besplatni Seminarski
Radovi
|
|